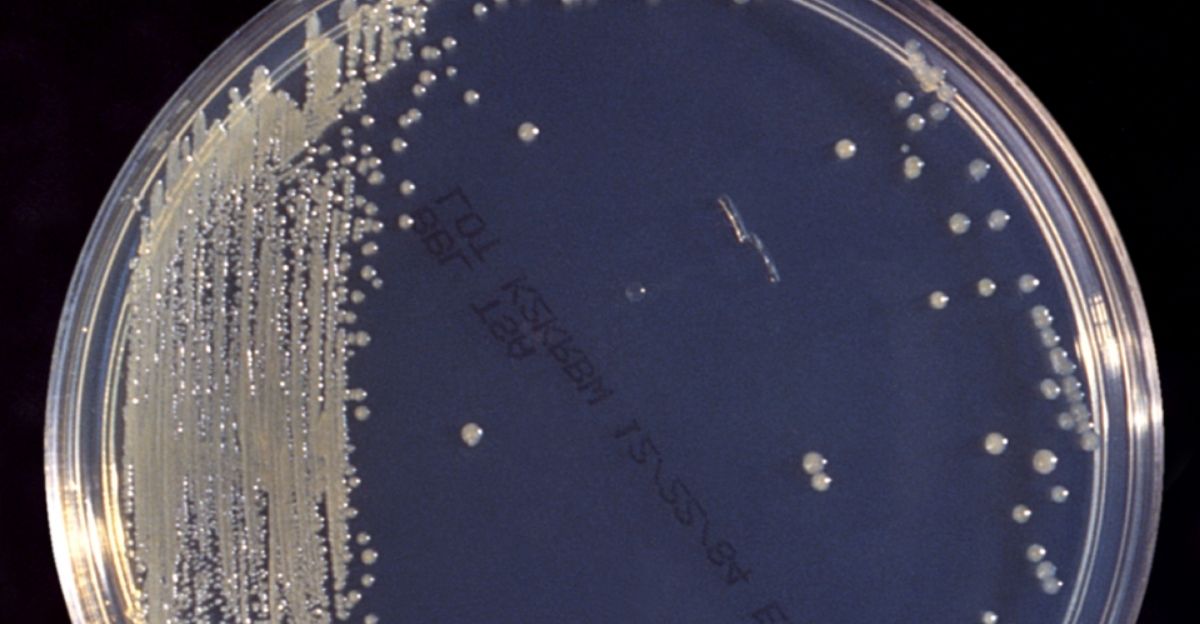

In the opening days of January 2026, one of the world’s largest food corporations faced a crisis that would become its largest product recall in 160 years of operations. Nestlé announced that more than 800 infant formula products across over 60 countries contained cereulide, a heat-resistant toxin produced by Bacillus cereus bacteria that cannot be destroyed by boiling water or standard formula preparation. The fallout quickly widened.
When Baby Formula Suddenly Felt Unsafe

Austrian health authorities called it the largest recall in Nestlé’s 160-year history. More than 800 infant formula products from 10+ factories across 60+ countries were pulled over cereulide contamination. No illnesses were confirmed yet, but the toxin cannot be destroyed by boiling. Parents faced a crisis: trusted nutrition could carry risks, and certainty was suddenly scarce.
However, the most alarming detail was what made this contaminant different.
A Toxin That Heat Cannot Defeat

Cereulide is produced by certain Bacillus cereus strains. Unlike many contaminants, it can be preformed in oil before it reaches consumers. The UK Food Standards Agency warned cereulide “is unlikely to be deactivated or destroyed by cooking, using boiling water, or when making the infant milk,” in guidance dated January 7, 2026. Symptoms can appear within 5 hours.
So why did families only hear about it after Christmas?
The Silent Christmas Recall Controversy

Austrian authorities said Nestlé conducted a “silent recall” during the Christmas holiday period without public warning. FoodWatch director Nicole van Gemert said on January 8, 2026: “For infant formula, a ‘silent’ recall is not an appropriate response when there is a potential unacceptable risk.” The revelation fueled anger over delayed disclosure and consumer protection failures.
Still, the dates behind the delay raised even more questions.
A Timeline That Left Consumers Exposed

Lab tests detected Bacillus cereus on November 26, 2025. Dutch authorities were notified on December 9. Yet the public global recall was not announced until January 5, 2026, nearly a month later. Individual countries began action in mid-December, but the full 60+ country scope stayed unclear until January.
Who knew which details, and when did they learn them?
Conflicting Claims About Where It Shipped

FoodWatch highlighted contradictions in Nestlé’s account. On December 15, after FoodWatch contacted Dutch authorities, they were told Nestlé confirmed no distribution in Netherlands or Belgium. Weeks later, both countries issued recalls. FoodWatch said January 8, 2026: “So either distribution did occur, or the risk assessment and scope changed, or traceability and communication failed.”
That contradiction pointed straight at supply-chain tracking weaknesses.
The Nunspeet Plant With Global Reach

The contamination was first identified at Nestlé’s Nunspeet plant in the Netherlands during routine self-monitoring. The facility exports infant nutrition products to about 140 markets. Dutch food safety authority NVWA confirmed on January 8, 2026 that contaminated raw material had been used at multiple sites, including facilities outside the Netherlands.
With exports that broad, containment was never going to be simple.
The Oil Ingredient At The Center

Nestlé traced the issue to arachidonic acid oil supplied by an unnamed third party. Yicai Global reported Cabio Biotech, a Wuhan supplier, was likely involved after its ARA revenue rose 29% to CNY390 million ($55.9 million) in 2024. Cabio stock fell 11.9% to CNY21.15 ($3.03), while it said testing was underway.
But Nestlé still did not officially name the supplier publicly.
The Recall Cost Estimate Gap

Nestlé said the affected batches were “significantly less than 0.5%” of annual group sales. Analysts disagreed. Jefferies estimated about 1.3% of group sales at risk, roughly CHF 1.2 billion ($1.5 billion). Barclays placed exposure between 0.8% and 1.5%. The spread signaled uncertainty about direct recall costs and long-term brand damage.
Markets wanted clarity, but the brand list kept expanding.
Brands Hit Differently By Country

In Europe, recalled products included SMA, BEBA, Nidal, Guigoz, Alfamino, Lactogen, and Nestlé Advanced Nutrition. The same formulas appeared under different names by market. UK and Ireland saw SMA recalls with expiry dates from October 2026 to November 2027. Germany recalled BEBA and Alfamino. Spain reported 36 batches across NAN variants.
Could quality systems really miss something this rare?
“The Presence of Cereulide in Oils is Very Uncommon”

Nestlé acknowledged: “The presence of cereulide in oils is very uncommon.” That raised questions about how it slipped through controls. Research shows cereulide can survive 121°C for over 2 hours, defeating standard industrial sterilization. It also resists pH 2 to 10, consistent with peer-reviewed findings on toxin stability. The rarity made the event feel less excusable.
Complicating matters, Nestlé leadership was already in transition.
A New CEO Thrown Into Crisis

Philipp Navratil became Nestlé CEO in September 2025 after Laurent Freixe was dismissed over an undisclosed romantic relationship with a subordinate. By October 2025, Navratil announced 16,000 job cuts over 2 years, about 6% of staff. Within months, he faced Nestlé’s largest recall ever. Investors wondered whether instability weakened oversight at the worst possible moment.
Yet another timeline detail suggested products circulated earlier than many realized.
Reports Of Sales Going Back To October

FoodWatch said potentially affected products were sold as early as October 2025, citing French authorities. France, Finland, and Denmark began recalls in mid-December. Yet the Netherlands, Belgium, Germany, and Ireland waited until January 5 for public recalls despite earlier knowledge. The staggered approach meant some consumers could have purchased affected formula for months without warnings.
Why did one country decide targeted batches were not enough?
Vietnam’s Blanket Ban Raises Stakes

Vietnam’s health ministry ordered a full halt to all Nestlé powdered milk sales under Beba and Alfamino, regardless of batch number. On January 7, 2026, regulators told e-commerce platforms to suspend listings and required Nestlé to report import volumes, sales, inventory, and remediation measures by January 10. Nestlé said it never imported recalled batches into Vietnam.
If a full ban was possible, what did regulators fear most?
Hospital Formulas Put Fragile Patients First

In New Zealand, Alfamino specialist formula was mainly distributed through hospitals, pharmacies, and GP prescriptions, not supermarkets. The recall affected infants with milk allergies relying on medical nutrition. New Zealand Food Safety deputy director Vincent Arbuckle warned January 8, 2026: “Infants are vulnerable to dehydration and parents should have a low threshold for contacting a GP or emergency room if the child experiences vomiting, abdominal pain or diarrhoea within the first 24 hours after ingestion.”
Even guidance on what to do next was not consistent.
Confusion Over What Parents Should Keep

Nestlé advised parents to destroy recalled products and dispose of them safely. FoodWatch advised the opposite: keep packaging as possible evidence for legal action. That disagreement confused families already focused on immediate safety. FoodWatch argued that if health issues later appeared, packaging and batch codes could prove exposure and strengthen lawsuits.
The legal angle grew sharper because this was not Nestlé’s first scare.
A Pattern That Deepened Public Doubt
Before this recall, Nestlé faced other 2025 safety issues. Belgium and Luxembourg recalled infant formula over Cronobacter spp. France recalled products due to ochratoxin A. FoodWatch said its lab tests found potentially carcinogenic mineral oil residues in Nestlé baby products. Nestlé also faced U.S. lawsuits alleging heavy metals in baby food. The repeated incidents amplified skepticism about safeguards.
With trust shaken, market share suddenly looked like a vulnerability.
The Market Size Makes Fallout Bigger

Nestlé held about 25% of the $92.2 billion global infant nutrition market. Infant nutrition accounted for 16.6% of Nestlé’s 2024 sales of CHF 91.4 billion ($102.4 billion). Past crises show lasting damage: Danone’s Dumex lost about €800 million ($931 million) after a 2013 China false alarm, and Abbott needed about 1 year to recover share after Similac recalls in 2010 and 2022.
Supplier Secrecy Fuels Accountability Demands

Nestlé said the unnamed supplier was “conducting a full root-cause analysis.” FoodWatch demanded public identification, arguing transparency prevents repeat harm. FoodWatch submitted 7 questions to Nestlé Netherlands and awaited responses. Nestlé said it worked with alternative suppliers and increased production elsewhere to reduce disruption. Still, without naming the supplier, consumers could not independently judge responsibility or broader industry risk.
Investors, too, watched for signals beyond public statements.
Investors Wait For February Clarity

Nestlé shares fell 4.6% after the recall expansion on January 5, 2026. Jefferies issued a “hold” rating and predicted “a dramatic but ultimately constructive reset year” for the company. Navratil is set to present 2025 annual results and 2026 guidance on February 19, 2026. Analysts will judge whether quality systems and traceability can be credibly rebuilt.
But the biggest question is what changes will remain after headlines fade.
Whether Reform Sticks Or Fades Away

As investigations continue, the infant nutrition industry is watching whether Nestlé makes systemic changes or returns to routine crisis playbooks. Regulators across Europe, Asia-Pacific, and the Americas will review whether existing frameworks protect vulnerable infants. Consumer trust remains fragile, and in infant nutrition it is everything. This recall could become a turning point for food safety reform, or another chapter in corporate damage control.
However, the sources behind this story reveal how the record was built.
Sources:
Nestlé infant formula product advisory. Nestlé Global Official Website, January 5-8, 2026
SMA infant formula and follow-on formula recall. Food Safety Authority of Ireland, January 5, 2026
Recall of specialist infant formula due to potential toxin. New Zealand Food Safety Official Advisory, January 8, 2026
Heat resistance of Bacillus cereus emetic toxin, cereulide. PubMed/NIH Research Study, May 2008
Nestlé’s Chinese ARA Supplier Plunges After Swiss Firm Issues Global Recall of Baby Formula. Yicai Global, January 8, 2026